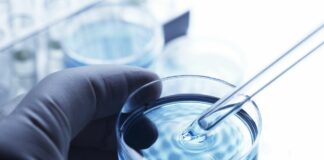
Farmaceutica, Takeda annuncia la rimborsabilità di Maribavir

Giuseppe Toro eletto presidente di Ail
PALERMO (ITALPRESS) - Giuseppe Toro è stato eletto presidente Nazionale di AIL - Associazione Italiana contro Leucemie, Linfomi e Mieloma dal nuovo Consiglio di...
Sanofi lancia la campagna “Vacciconcura” per viaggiatori più consapevoli
MILANO (ITALPRESS) - Con l'arrivo della bella stagione torna anche la voglia di partire per staccare la spina. Rispetto al calo dovuto alla pandemia,...
Arriva in Italia un nuovo farmaco contro la leucemia mieloide cronica
MILANO (ITALPRESS) - La complessità di essere costretti, a un certo punto della terapia, a cambiare strada: è l'esperienza di chi convive con la...
Trapianto di tessuto adiposo, Ortopedici a confronto a Palermo
PALERMO (ITALPRESS) - Il "Trapianto di Tessuto Adiposo: la nuova frontiera in campo ortopedico" è il tema dell'incontro che si terrà presso l'Unità di...
Farmaceutica, Takeda annuncia la rimborsabilità di Maribavir
ROMA (ITALPRESS) - Takeda Italia annuncia che, con la pubblicazione della determina AIFA (Agenzia Italiana del Farmaco) n. 424 nella Gazzetta del 22 giugno...
Realtà virtuale immersiva al Pronto soccorso del Gemelli ed i bimbi...
ROMA (ITALPRESS) - "Somministrare" a un bambino la realtà virtuale sotto forma di giochi o storie interattive, durante un trattamento o una procedura invasiva,...
Monaco “Enorme importanza educazione continua in Medicina”
ROMA (ITALPRESS) - L'importanza dell'educazione continua in medicina "è enorme perchè vuol dire dare ai nostri cittadini delle performance sanitarie di qualità. I nostri...
Rapporto Crea sanità, 8 regioni promosse
ROMA (ITALPRESS) - Otto Regioni/Province autonome (di cui tre migliori delle altre) promosse, sette "rimandate" e sei "bocciate" alla prova delle Performance 2023, valutate...